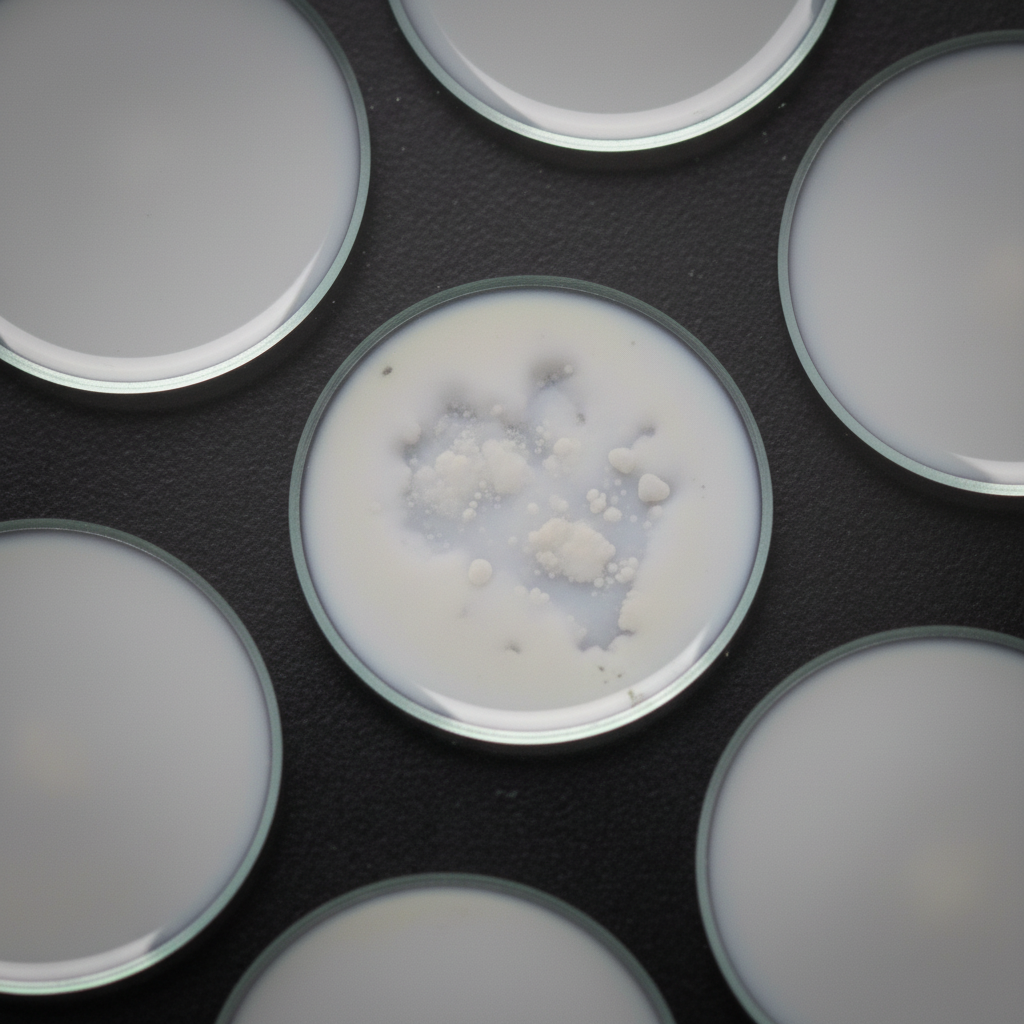
Image for question 1204

Enter your email to get your 85% OFF code and unlock the full NEET PG question bank on the app.
Ureter develops from:
At what age does a child typically reach a height of 100 cm?
MCH class 3 genes encode which of the following?
The above condition is positive in which of the following stages of syphilis?
Which is the only cranial nerve that does not have a ventral attachment at the base of the brain?
Two drugs having opposite actions on different receptors demonstrate which type of antagonism?
Which of the following are regulator proteins?
Which of the following cranial nerves has no somatic motor nucleus?
Which drug blocks both H1 and 5-HT2 receptors?
The common carotid artery is formed by which embryonic aortic arch?
Organization of the Nervous System
Practice Questions
Spinal Cord Anatomy
Practice Questions
Brainstem Anatomy
Practice Questions
Cerebellum
Practice Questions
Diencephalon
Practice Questions
Cerebral Cortex
Practice Questions
Basal Ganglia
Practice Questions
Limbic System
Practice Questions
Cranial Nerves
Practice Questions
Autonomic Nervous System
Practice Questions
Neural Pathways and Tracts
Practice Questions
Neurovascular Anatomy
Practice Questions
Get full access to all questions, explanations, and performance tracking.
Scan to download app